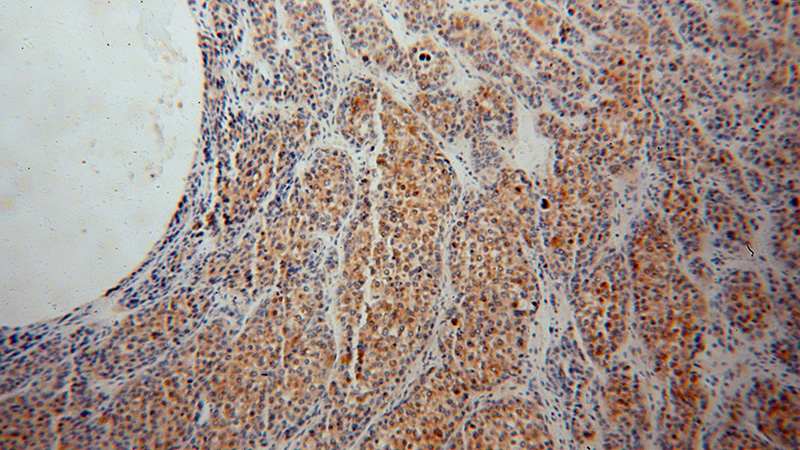
Immunohistochemical of paraffin-embedded human liver cancer using Catalog No:115228(SIGMAR1 antibody) at dilution of 1:50 (under 10x lens)

-
Product Name
SIGMAR1 antibody
- Documents
-
Description
SIGMAR1 Rabbit Polyclonal antibody. Positive IHC detected in human liver cancer tissue. Positive WB detected in mouse kidney tissue, mouse brain tissue, mouse colon tissue. Observed molecular weight by Western-blot: 27 kDa
-
Tested applications
ELISA, WB, IHC
-
Species reactivity
Human,Mouse,Rat; other species not tested.
-
Alternative names
FLJ25585 antibody; hSigmaR1 antibody; OPRS1 antibody; SIG 1R antibody; Sigma 1 type opioid receptor antibody; Sigma1 receptor antibody; Sigma1R antibody; SIGMAR1 antibody; SR BP antibody; SR BP1 antibody; SR31747 binding protein antibody; SRBP antibody
-
Isotype
Rabbit IgG
-
Preparation
This antibody was obtained by immunization of SIGMAR1 recombinant protein (Accession Number: NM_005866). Purification method: Antigen affinity purified.
-
Clonality
Polyclonal
-
Formulation
PBS with 0.02% sodium azide and 50% glycerol pH 7.3.
-
Storage instructions
Store at -20℃. DO NOT ALIQUOT
-
Applications
Recommended Dilution:
WB: 1:200-1:2000
IHC: 1:20-1:200
-
Validations

mouse kidney tissue were subjected to SDS PAGE followed by western blot with Catalog No:115228(SIGMAR1 antibody) at dilution of 1:500

Immunohistochemical of paraffin-embedded human liver cancer using Catalog No:115228(SIGMAR1 antibody) at dilution of 1:50 (under 40x lens)
Immunohistochemical of paraffin-embedded human liver cancer using Catalog No:115228(SIGMAR1 antibody) at dilution of 1:50 (under 10x lens)
-
Background
SIGMAR1, also named as OPRS1, SRBP, SIG-1R and AAG8, belongs to the ERG2 family. It is an endoplasmic reticulum chaperone that binds a wide variety of ligands, including neurosteroids, psychostimulants, and dextrobenzomorphans. SIGMAR1 is ubiquitously expressed, and is enriched in motor neurons of the brain and spinal cord. It plays a role in calcium signaling through modulation together with ANK2 of the ITP3R-dependent calcium efflux at the endoplasmic reticulum. SIGMAR1 plays a role in several other cell functions including proliferation, survival and death. SDS-PAGE and Western blot analysis showed that SIGMAR1 has an apparent molecular mass of 28 kDa. SIGMAR1 has 5 isoforms with MW 21-27kDa and 12kDa.
-
References
- Lim Y, Cho IT, Schoel LJ, Cho G, Golden JA. Hereditary spastic paraplegia-linked REEP1 modulates endoplasmic reticulum/mitochondria contacts. Annals of neurology. 78(5):679-96. 2015.
Related Products / Services
Please note: All products are "FOR RESEARCH USE ONLY AND ARE NOT INTENDED FOR DIAGNOSTIC OR THERAPEUTIC USE"
